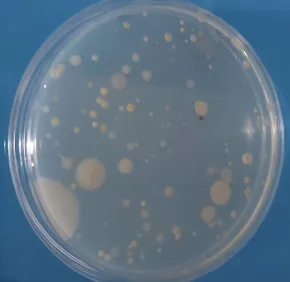
Adaptation microbienne

Actualités et événements
Actualité

Spectroscopie femtoseconde et modélisation moléculaire révèlent de nouveaux aspects de la photochimie des flavines
Spectroscopie femtoseconde et modélisation moléculaire révèlent de nouveaux aspects de la photochimie des flavines
En savoir plus
23.10.2025
Des chercheurs du LOB Ecole Polytechnique et du CEA Cadarache dévoilent les dynamiques de photooxydation ultrarapide du cofacteur flavine dans la photoenzyme naturelle fatty acid photodecarboxylase (FAP). Grâce à la spectroscopie d’absorption transitoire...
Actualité

Au-delà de la séquence : quand la structure de l’ADN régule les gènes
Au-delà de la séquence : quand la structure de l’ADN régule les gènes
En savoir plus
19.08.2025
Des chercheurs du Laboratoires d'optique et biosciences ont participé à une étude montrant que certaines structures en trois dimensions de l’ADN, les G-quadruplexes, jouent un rôle clé dans la régulation de l’expression des gènes chez les mammifères. Ce...
Actualité

Des défauts dans les gènes de réparation de l’ADN favorisent l’émergence de la résistance aux antimicrobiens chez Mycobacterium tuberculosis
Des défauts dans les gènes de réparation de l’ADN favorisent l’émergence de la résistance aux antimicrobiens chez Mycobacterium tuberculosis
En savoir plus
13.05.2025
Le problème croissant de la résistance aux antibiotiques aggrave le fardeau social et économique de la tuberculose (TB) causée par Mycobacterium tuberculosis ( Mtb ). Grâce à des analyses génomiques à grande échelle et à l’édition du génome, des...
Les chiffres-clés
25
Chercheur.e.s et enseignant.e.s-chercheur.e.s
14
personnels d'appui à la recherche
27
doctorant.e.s ou chercheur.e.s post-doctorant.e.s
20
salles d’expérience
32
collaborations internationales
22
brevets